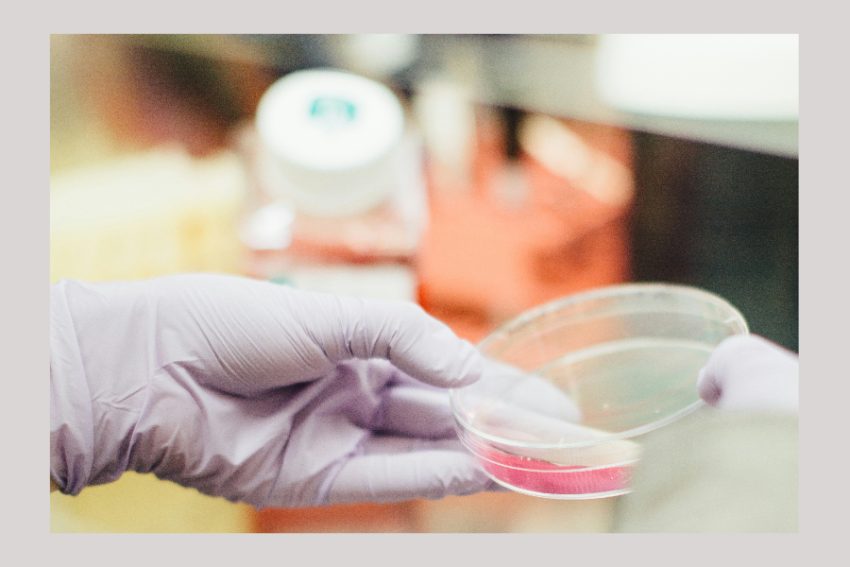
analiza laborator microscop celule analiza laborator microscop celule

Direcția de Sănătate Publică a Municipiului București a fost informată de Spitalul Clinic de Boli Infecțioase și Tropicale “Dr. Victor Babeș” cu privire la confirmarea, prin analize de laborator, a unui caz de malarie, transmite Ministerul Sănătății.
Pacientul este un bărbat în vârstă de 69 de ani, cu domiciliul în București. Acesta se află în stare stabilă și urmează tratament medicamentos specific.
Potrivit sursei citate bucureșteanul nu a călătorit recent în străinătate.
La acest moment Direcția de Sănătate Publică a Municipiului București derulează o anchetă epidemiologică, conform metodologiei specifice.
De precizat faptul că de la începutul anului, în țara noastră au fost raportate 21 de cazuri de malarie, toate cu istoric de călătorie în țări endemice de malarie.

Foto: IStock
Ce este malaria?
Malaria este o boală infecțioasă care se transmite prin înțepătura de țânțar (specia Anopheles) iar profilaxia constă în administrarea unor medicamente antimalarice și protecție împotriva înțepăturilor de țânțari, informează Ministerul Sănătății.
Informații suplimentare cu privire la malarie și alte boli tropicale care pot fi asociate călătoriei găsiți pe site-ul Institutului Național de Sănătate Publică:

Foto: Facebook Ministerul Sănătății
Pentru a preveni îmbolnăvirile prin boli transmise prin ţanţari amintim recomandările făcute de Ministerul Sănătății:
- Evitarea expunerii la înțepaturi de țânțar între apusul de soare și zorii zilei când țânțarii au cea mai mare activitate sau utilizarea de haine cu mâneci lungi, pantaloni lungi și sosete în aceasta perioada.
- Utilizarea de substanțe repelente conținând DEET (N,N-diethyl-3- methylbenzamide) pe părțile neacoperite ale corpului.
- Evitarea pătrunderii țânțarilor în case prin închiderea ușilor și a ferestrelor sau prin punerea de plase la uși și ferestre.
- Utilizarea de benzi impregnate cu permethrin în zonele unde nu este posibilă evitarea intrării țânțarilor în camera de dormit.
- Utilizarea în interiorul locuinței de spray-uri sau alte produse cu insecticide
- Utilizarea de permethrin, piretroid cu caracteristici insecticide, prin aplicarea pe haine (impregnarea hainelor militare,
- Impregnarea hainelor persoanelor care lucreză noaptea pe câmp), pe plasele pentru țânțari, pereții cortului sau alte materiale, dar nu pe piele.
- Eliminarea apei stagnate prin golirea recipientelor de colectare a apei pluviale, a jardinierelor, a bidoanelor și a găleților, îndepărtarea anvelopelor uzate din curți, curățarea jgheaburilor înfundate, îndepărtarea gunoiului menajer
Foto descriptiv
Citiți, de asemenea, pe anchetaonline.ro